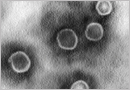

지루 피부염

지루성피부염은 두피, 안면 및 상부 체간 등 피지의 분비가 많은 신체 부위에 국한하여 홍반과 인설을 특징으로 하는 만성 염증성 질환입니다. 비듬은 두피의 과다한 인설을 특징으로 하는 비염증성 상태로서, 이를 지루성피부염에 포함하기도 합니다.
아동학대

심리적으로나 육체적으로 발달상태에 있는 미완의 아동이 학대에 의해 신체적 건강과 정신적 건강이 침해되면 향후 성장과 발달에 치명적인 영향을 미칠 수밖에 없게 됩니다.
알레르기(일반)

알레르기에 대해 이해하려면 우선 정상적인 인체의 면역 시스템에 대한 이해가 필요합니다. 면역반응에는 형태학적으로 또는 기능적으로 다양한 기관과 조직들이 관여하는데 이들을 기능상 1차 림프기관 (중추 림프기관)과 2차 림프기관(말초림프기관)으로 나눌 수 있습니다.
소아뇌종양

뇌종양이란 두개골 내에 생기는 모든 종양을 말하며 뇌 및 뇌 주변 구조물에서 발생하는 모든 종양을 포함합니다. 소아 뇌종양은 소아암 중에서 백혈병 다음으로 흔하고 고형 종양 중 제일 흔한 종양입니다.
폴리오
폴리오바이러스는 장내배설물을 통해 전파되기 때문에 무엇보다도 격리가 중요합니다. 집에서 치료하는 환자의 경우에는 발병 전에 이미 노출이 되었기 때문에 격리필요성이 감소됩니다.
풍진

비교적 가벼운 임상경과를 거치는 질환으로서 특별한 이상증상을 나타내지 않는 불현성(不現性) 감염도 흔하며, 특징적으로 귀 뒤, 목 뒤, 후두부의 림프절이 통증을 동반하며 종대됩니다.
홍역

홍역은 중이염, 기관지염, 모세기관지염, 기관지폐렴, 크룹 등의 호흡기계 합병증과 설사(영아), 급성뇌염, 아급성 경화성 뇌염(Subacute sclerosing panencephalitis, SSPE) 등의 합병증을 남기기도 합니다.
회충증

회충증은 오염된 날 채소, 상추 쌈, 김치, 먼지 등을 입으로 섭취하여 전파됩니다.
소아림프종

소아림프종은 생물학적 특성에 따라 호지킨림프종과 비호지킨림프종으로 나뉘어집니다. 두 질환은 같은 림프 조직에서 발병하지만 임상 증상, 경과, 병태 생리, 치료 방법 등이 완전히 차이가 나 별개의 질환으로취급할 수밖에 없습니다.
일본뇌염

일본뇌염바이러스에 의해 감염된 빨간 집모기 (Cule tritaeniorhynchus)가 다시 사람을 감염시켜 뇌신경을 침범하는 전염병으로서 유행성 뇌염에 속합니다.